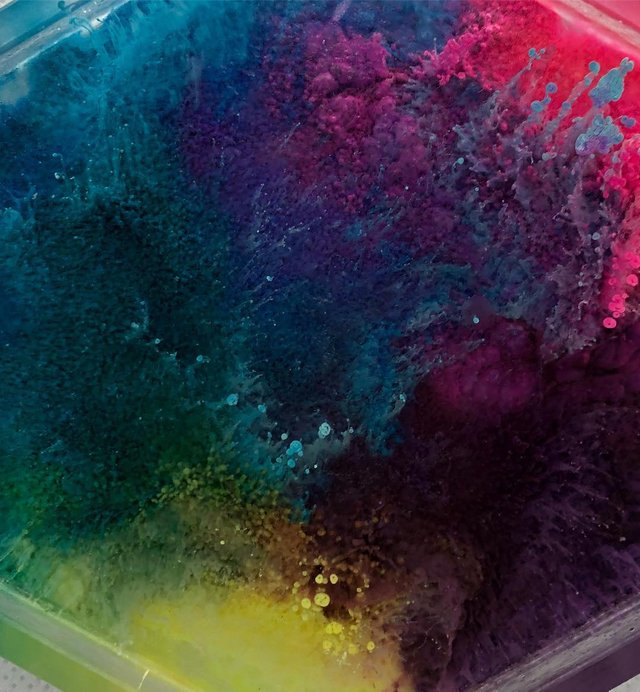

RareandShiny: 2019/01/05 03:41:15

Already in love with this hexagon trinket holder! Would be great to put small jewelry and earrings in or store screws while taking something apart to keep track of them. .
.
.
#rareandshiny #resinjewelry #resinartist #resin #resinart #alcoholink #fluidart #demolding #resincharms #resincraft #resinmolds #share2steem


rareandshiny
